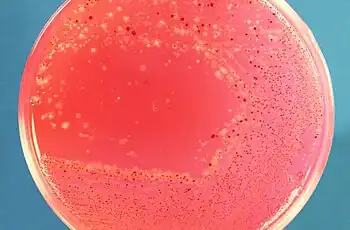

Prevotella melaninogenica
| Prevotella melaninogenica | |
|---|---|
![]() | |
| Scientific classification | |
| Domain: | |
| Phylum: | |
| Class: | |
| Order: | |
| Family: | |
| Genus: | |
| Species: | P. melaninogenica |
| Binomial name | |
| Prevotella melaninogenica (Oliver and Wherry 1921) Shah and Collins 1990[1] | |
| Synonyms | |
|
Bacteroides melaninogenicus | |
Prevotella melaninogenica is a species of bacterium in the normal microbiota of the upper respiratory tract. It is an important human pathogen in various anaerobic infections, often mixed with other aerobic and anaerobic bacteria.[2] P. melaninogenica is an anaerobic, Gram-negative rod, named for its black colonies, and black pigment.
P. melaninogenica is associated with hypertension together with Campylobacter rectus and Veillonella parvula.[3]
Morphology
P. melaninogenica are Gram-negative rod-shaped bacteria. They cannot survive in the presence of oxygen. They are not motile, and do not form spores. P. melaninogenica grow well on blood agar, where they form circular dark-colored colonies that darken over one to two weeks.[4]
History
P. melaninogenica was originally described as Bacteroides melaninogenicus in 1921 by Wade Oliver and William Wherry at the University of Cincinnati as a new bacterium isolated from various sites of several different human patients.[1][5] In 1982, Lillian Holdeman and John Johnson determined that some bacteria previously described as B. melaninogenicus were actually a distinct species, which they named Bacteroides loescheii.[1][4] In 1990, Haroun Shah and David Collins at the London Hospital Medical College reclassified several species of Bacteroides, including B. melanogenicus under a new genus called Prevotella. With this, B. melaninogenicus was renamed to Prevotella melaninogenica.[1][6]
References
- 1 2 3 4 Parte, A.C. "Bacteroides". LPSN. Archived from the original on 20 February 2020. Retrieved 3 February 2018.
- ↑ 93. Brook, I.: “Anaerobic Infections Diagnosis and Management”. A Textbook. Informa Healthcare USA, Inc. New York. 2007.
- ↑ Pietropaoli, Davide; Del Pinto, Rita; Ferri, Claudio; Ortu, Eleonora; Monaco, Annalisa (August 2019). "Definition of hypertension-associated oral pathogens in NHANES". Journal of Periodontology. 90 (8): 866–876. doi:10.1002/JPER.19-0046. ISSN 1943-3670. PMID 31090063. S2CID 155089995.
- 1 2 Holdeman, L. V; Johnson, J. L (1982). "Description of Bacteroides loescheii sp. nov. And Emendation of the Descriptions of Bacteroides melaninogenicus (Oliver and Wherry) Roy and Kelly 1939 and Bacteroides denticola Shah and Collins 1981". International Journal of Systematic Bacteriology. 32 (4): 399. doi:10.1099/00207713-32-4-399.
- ↑ Oliver, W. W; Wherry, W. B (1921). "Notes on some bacterial parasites of the human mucous membranes". Journal of Infectious Diseases. 28 (4): 341. doi:10.1093/infdis/28.4.341. Archived from the original on 2023-10-20. Retrieved 2023-08-01.
- ↑ Shah, H. N; Collins, D. M (1990). "NOTES: Prevotella, a New Genus to Include Bacteroides melaninogenicus and Related Species Formerly Classified in the Genus Bacteroides". International Journal of Systematic Bacteriology. 40 (2): 205–8. CiteSeerX 10.1.1.319.5672. doi:10.1099/00207713-40-2-205. PMID 2223612.
